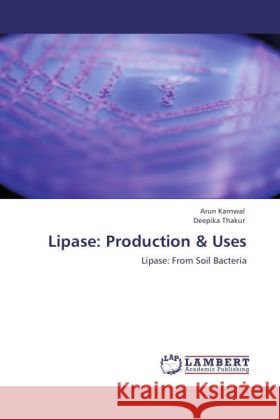
Lipase: Production & Uses Arun Karnwal, Deepika Thakur 9783847349501 LAP Lambert Academic Publishing - książka

Lipase: Production & Uses » książka
topmenu
Lipase: Production & Uses
ISBN-13: 9783847349501 / Angielski / Miękka / 2012 / 68 str.
Kategorie:
Kategorie BISAC:
Wydawca:
LAP Lambert Academic Publishing
Język:
Angielski
ISBN-13:
9783847349501
Rok wydania:
2012
Dostępne języki:
Angielski
Ilość stron:
68
Waga:
0.11 kg
Wymiary:
22.922.9 x 15.222.9 x 15.2 x 0
Oprawa:
Miękka